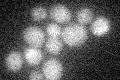
YJL038C
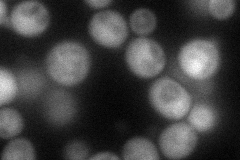
YJL038C
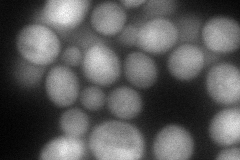
YJL038C
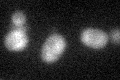
YJL038C

View description
Protein of unknown function with proposed roles in maintenance of genome integrity and also in spore wall assembly; induced during sporulation; repressed during vegetative growth by Sum1p and Hst1p; sequence similar to IRC1
Localization:
Intensity:
Fold change:
Significance:
-
C’ GFP library in SD
below threshold16.13 -
N' NOP1pr-GFP in SD
cytosol72.9177 -
N' TEF2pr-mCherry in SD
cytosol104.21 -
N' NATIVEpr-GFP in SD

below threshold17.9112 -
N' TEF2pr-VC and Cyto-VN in SD

below threshold24.2484 -
C’ GFP library in SD+DTT
cytosol18.261.13No -
C’ GFP library in SD+H2O2

cytosol14.050.87No -
C’ GFP library in Starvation Media

cytosol15.160.93No -
C’ GFP library on the background of Pup2-DaMP

below threshold -
C’ GFP library on the background of CCT mutant

below threshold17.4451.08115No
